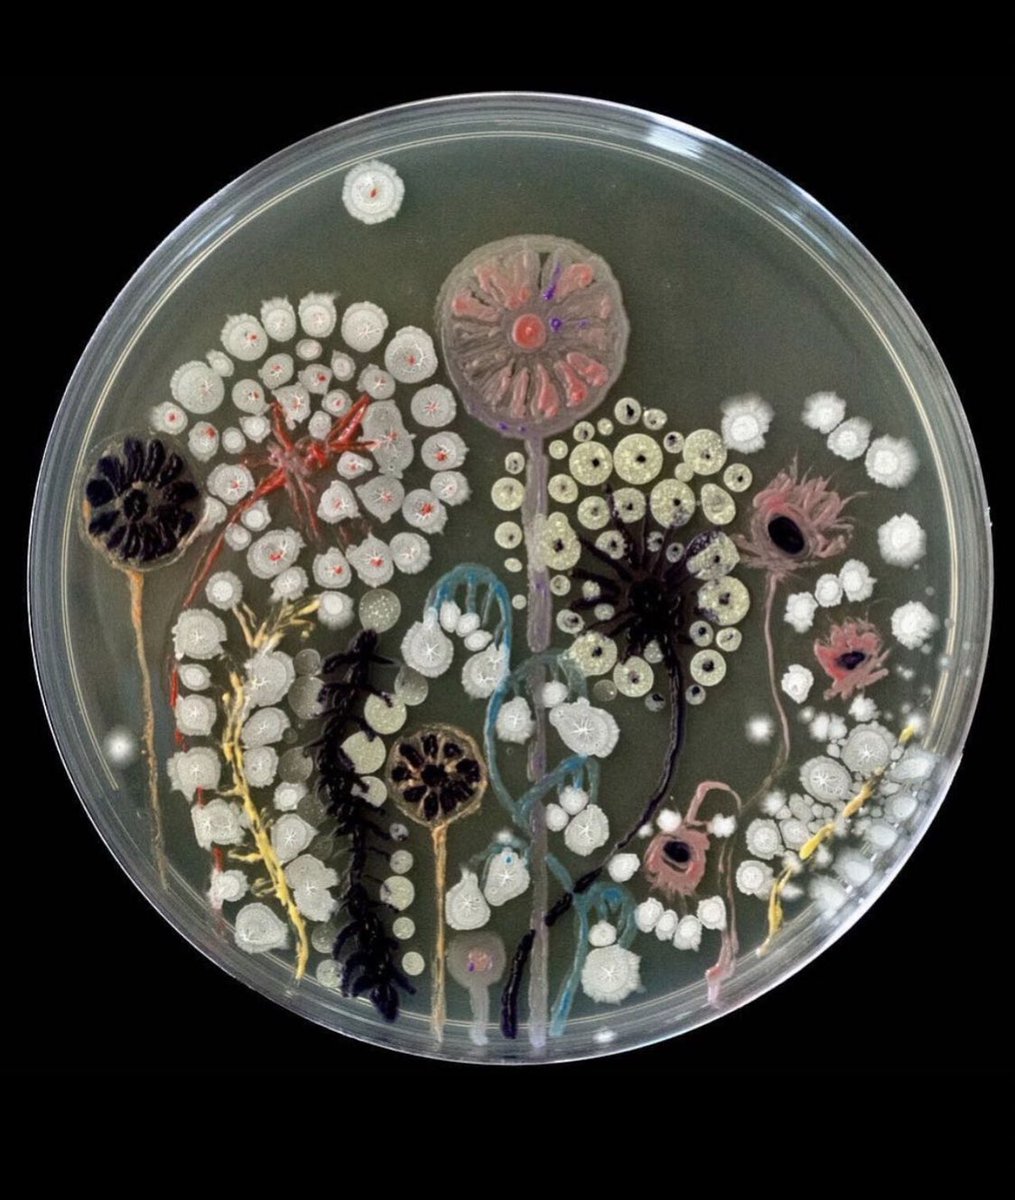
Las placas Petri deben su nombre al científico que dio lugar a esta idea, Julius Richard Petri. 
No solo tienen su utilidad en el laboratorio, sino que además se ven cosas tan bonitas como estas 👇🏻

MicroSpec Research Group
@maldimaranon
MALDI-TOF mass spectrometry, Infrared Spectroscopy, Identification, Antimicrobial Susceptibility Test, Bacterial Typing...
ID: 1451136832767471622
21-10-2021 10:42:56
30 Tweet
36 Takipçi
36 Takip Edilen






Keen on visiting #Prague? Except for #charlesbridge, historical center, or #PragueCastle, we have an alternative! Czech Museum of #MassSpectrometry at IOCB Prague. Founded by Josef Cvačka. bit.ly/3vLWgXv Have you heard about any other MS museum around the world?

Imos comezar o seminario sobre o repositorio institucional da Universidade de Vigo e o Open Acess, estamos próximos á Semana Internacional do Acceso Aberto #OpenAccess #OpenData #AcademicTwitter Cultura Científica UVigo


Inscripciones gratuitas: uitb.cat Gracias a: @salutpublicabcn Sarah SEMERGEN | Médicos de AP @GeSIDA SEIMC SEE SeparRespira CIBER ISCIII Salut OtsukaES Vircell QIAGEN Cepheid Abbott DiaSorin #leti Serveis Clínics #archivel Sandoz




We have published a multicentric paper about the direct identification of microorganisms present blood culture bottles using the rapid BACpro II kit from #Nittobo mdpi.com/2075-4418/11/1… Marina Andre Ingebretsen David Rodríguez-Temporal 🧫🔬🦠🥼🧪

O ciclo de charlas Mulleres na Ciencia organizado pola Facultade de Química e Delegación Química está a contar coa presenza de diferentes personalidades femininas do mundo científico. 👇


El próximo martes 22 de marzo estaremos en la Jornada del Día Mundial de la Tuberculosis de la UITB presentando nuevos estudios del MALDI-TOF en micobacterias. Inscripciones gratuitas: uitb.cat. MicroSpec Research Group Microbiología e Infecciosas Gregorio Marañón



Our last 2022 paper is finally out!! sfamjournals.onlinelibrary.wiley.com/doi/full/10.11… David Rodríguez-Temporal it is great to close the year this way!! Nuestro último paper de 2022 sfamjournals.onlinelibrary.wiley.com/doi/full/10.11… 🦠🔬🧫🧪🖥️🧮📈📊

La materia sobre "La inversión privada en I+D+i" estará a cargo de nuestro consejero Rafael Domenech | @BBVAResearch & @UV_EG Contamos con los mejores científicos y profesionales para compartir su experiencia en el programa #GEDIIT Infórmate🧐y solicita tu plaza 🎓: gadeaciencia.org/gediit/ #CulturaGadea


doi.org/10.1155/2023/8… New paper! Detection of Pseudomonas aeruginosa ST175 by FTIR and MALDI-TOF MicroSpec Research Group Microbiología e Infecciosas Gregorio Marañón

We have finally published our study about typing P. aeruginosa using #MALDI and #FTIR 🥳We are very proud of this article 🎉🎉🎉doi.org/10.1155/2023/8… Thank you Clover Biosoft for your support 🍀🍀🍀#HGM_MALDI_group you're amazing!!!🤩🤩🤩🤩Ana Candela David Rodríguez-Temporal 🦠📈🔬🧫🧪🥼📊